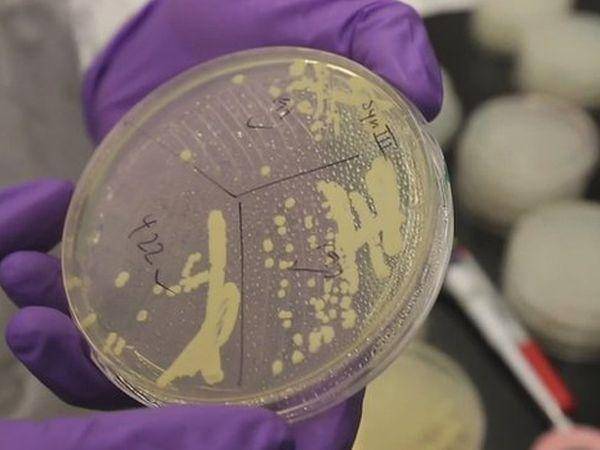

Category: Da li znate


Naučnici oživeli mahovinu zaleđenu više od 1.500 godina

Otkriveni fosilni ostaci kitova od pre 500 miliona godina
Proizveli sintetički hromozom pivskog kvasca

Origami mikroskop

Swim Spa Luxema 8000 kada sa bazenom

Interaktivni sto za naručivanje pizze

Električni auto na baterije od tečnih ćelija

Kina testira droneove za smrzavanje smoga
